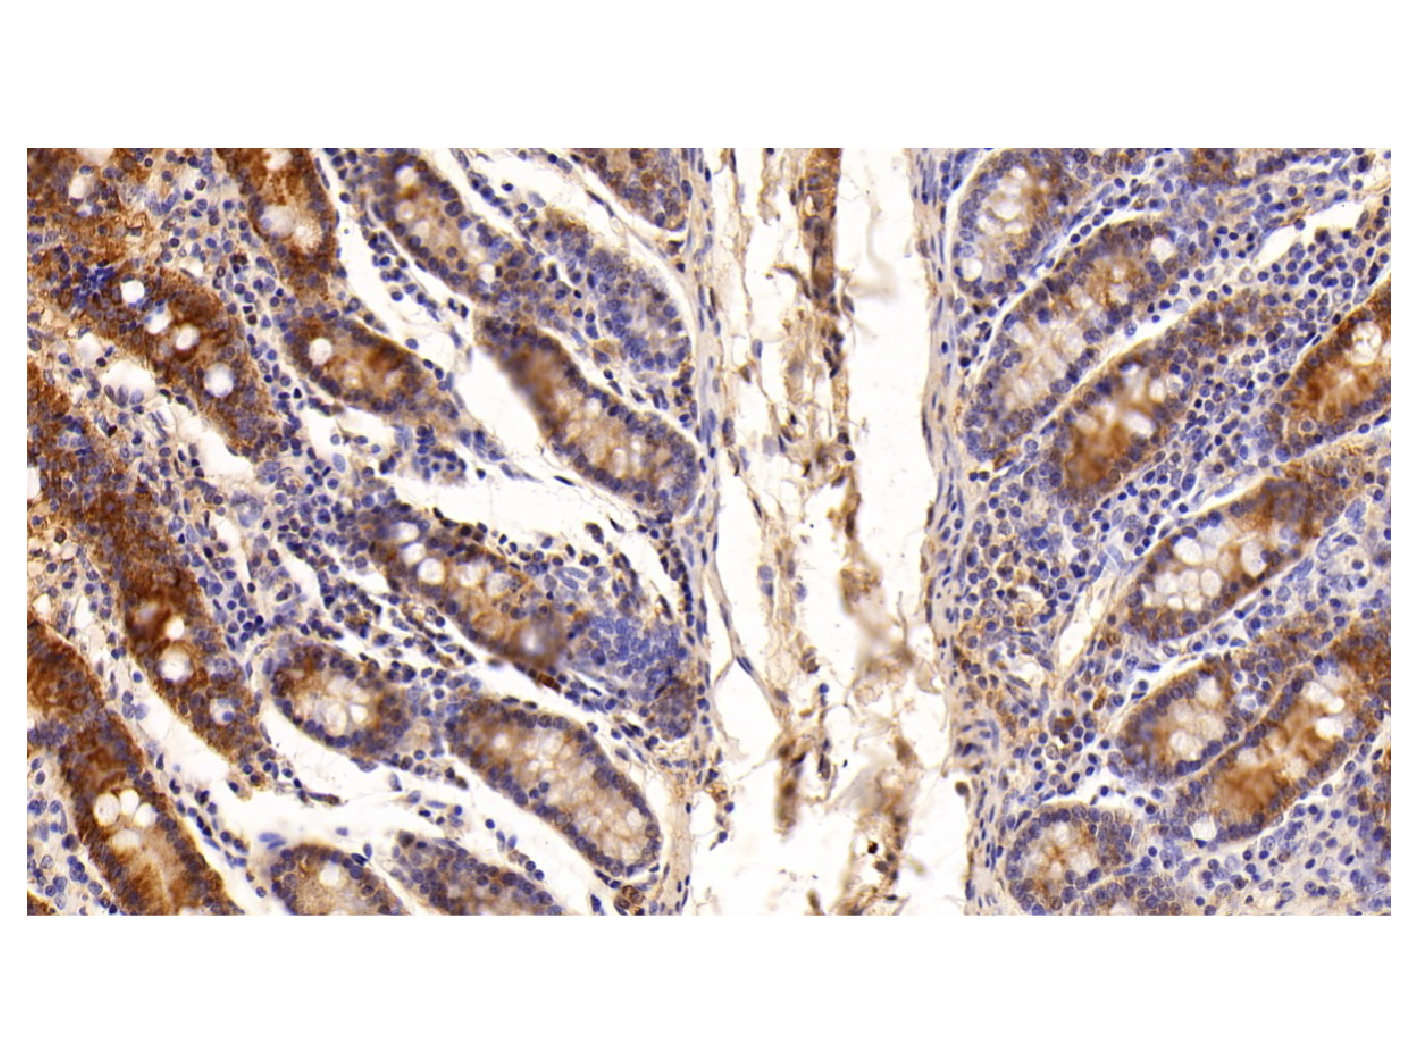

计算溶液所需的质量、体积或浓度。
This is a demo store. No orders will be fulfilled.

| 货号 (SKU) | 包装规格 | 是否现货 | 价格 | 数量 |
|---|---|---|---|---|
| Ab104584-10μl |
10μl |
现货  |
| |
| Ab104584-50μl |
50μL |
现货  |
| |
| Ab104584-100μl |
100μL |
现货  |
| |
| Ab104584-1ml |
1ml |
期货  |
|
| 产品名称 | Galectin 3 Antibody |
|---|---|
| 别名 | anti-GAL3抗体 | 半乳糖凝集素3多克隆抗体 | 半乳糖凝集素3抗体 |
| 英文别名 | 35 kDa lectin antibody | Carbohydrate binding protein 35 antibody | Carbohydrate-binding protein 35 antibody | CBP 35 antibody | CBP35 antibody | Gal-3 antibody | GAL3 antibody | Galactose-specific lectin 3 antibody | Galactoside-binding protein antibody |
| 规格或纯度 | 无载体, ExactAb™, 无叠氮钠, 已验证, 高性能, 见COA |
| 宿主种属 | 兔(Rabbit) |
| 特异性 | Galectin 3 |
| 种属反应性 | 人(Human),大鼠(Rat),小鼠(Mouse),猪(Pig) |
| 免疫原 | Recombinant Galectin 3 expressed in E.coli (AA 1-250) |
| 阳性对照 | WB: C6, NIH/3T3, Hep G2, A549, HeLa, MCF7 and A431 cell lysates. IHC: Human colorectal cancer, lung cancer, ovarian cancer tissues; Porcine small intestine, kidney and spleen tissues. IHC: MCF7 cells. |
| 偶联 | Unconjugated |
| 克隆类型 | 多克隆抗体 |
|---|---|
| Format | Whole IgG |
| 亚型 | Rabbit IgG |
| SDS-PAGE | 150 kDa |
| 纯化方法 | Antigen affinity purified and Protein A purified |
| 物理外观 | Liquid |
| 储存缓冲液 | 10mM PBS, 50% Glycerol, 0.05% Proclin 300, pH7.4 |
| 防腐剂 | 0.05% Proclin 300 |
| 浓度 | 见COA |
| 储存温度 | -20°C储存,避免反复冻融 |
| 运输条件 | 超低温冰袋运输 |
| 稳定性与储存 | 4℃ 短期储存(1-2 周)。-20℃长期保存(24 个月)。收货后建议分装。避免冷冻/解冻循环。 |
| 分子类型 | 抗体 |
| 作用机制 | Action Type | target ID | Target Name | Target Type | Target Organism | Binding Site Name | 参考文献 |
|---|

Galectin 3 Antibody (Ab104584) - Western Blot
All lanes: Galectin 3 Antibody (Ab104584) at 1/1000 dilution
Samples: Lysates at 20 µg per lane
Secondary: Goat Anti-Rabbit IgG H&L (HRP) (Ab170144) at 1/20000 dilution
Predicted band size: 28 kDa
Observed band size: 29 kDa
Exposure time: 0.1 s

Galectin 3 Antibody (Ab104584) - IF
FITC staining on IF
Samples: Human MCF7 cells
Primary Ab: 20 μg/mL Galectin 3 Antibody (Ab104584)
Second Ab: 1 μg/ml FITC-Linked Caprine Anti-Rabbit IgG Polyclonal Antibody.

Galectin 3 Antibody (Ab104584) - IHC
DAB staining on IHC
Samples: Human Colorectal cancer Tissue
Primary Ab: 10 μg/mL Galectin 3 Antibody (Ab104584)
Second Ab: 2 µg/mL HRP-Linked Caprine Anti-Rabbit IgG Polyclonal Antibody.

Galectin 3 Antibody (Ab104584) - IHC
DAB staining on IHC
Samples: Human Lung cancer Tissue
Primary Ab: 10 µg/mL Galectin 3 Antibody (Ab104584)
Second Ab: 2 µg/mL HRP-Linked Caprine Anti-Rabbit IgG Polyclonal Antibody.

Galectin 3 Antibody (Ab104584) - IHC
DAB staining on IHC
Samples: Human Ovarian cancer Tissue
Primary Ab: 10 µg/mL Galectin 3 Antibody (Ab104584)
Second Ab: 2 µg/mL HRP-Linked Caprine Anti-Rabbit IgG Polyclonal Antibody.
Galectin 3 Antibody (Ab104584) - IHC
DAB staining on IHC
Sample: Porcine Small intestine Tissue
Primary Ab: 10 µg/mL Galectin 3 Antibody (Ab104584)
Second Ab: 2 µg/mL HRP-Linked Caprine Anti-Rabbit IgG Polyclonal Antibody.

Galectin 3 Antibody (Ab104584) - IHC
DAB staining on IHC
Sample: Porcine Kidney Tissue
Primary Ab: 10 µg/mL Galectin 3 Antibody (Ab104584)
Second Ab: 2 µg/mL HRP-Linked Caprine Anti-Rabbit IgG Polyclonal Antibody.

Galectin 3 Antibody (Ab104584) - IHC
DAB staining on IHC
Sample: Porcine Spleen Tissue
Primary Ab: 10 µg/mL Galectin 3 Antibody (Ab104584)
Second Ab: 2 µg/mL HRP-Linked Caprine Anti-Rabbit IgG Polyclonal Antibody.
| 应用名称 | 稀释比例 |
|---|---|
| IHC | 5-20 µg/mL |
| IF/ICC |
5-20 µg/mL
|
| WB | 0.1-2 µg/mL |
通过匹配包装上的批号来查找并下载产品的 COA,每批产品都进行了严格的验证,您可放心使用!
| 批号(Lot Number) | 证书类型 | 货号 |
|---|---|---|
| 分析证书 | Ab104584 | |
| 分析证书 | Ab104584 | |
| 分析证书 | Ab104584 |
| 1. Oberg CT, Blanchard H, Leffler H, Nilsson UJ.. (2008) Protein subtype-targeting through ligand epimerization: talose-selectivity of galectin-4 and galectin-8.. Bioorg Med Chem Lett, 18 (13): (3691-3694). [PMID:18539029] [10.1016/j.bmcl.2008.05.066] |
| 2. Delaine T, Cumpstey I, Ingrassia L, Le Mercier M, Okechukwu P, Leffler H, Kiss R, Nilsson UJ.. (2008) Galectin-inhibitory thiodigalactoside ester derivatives have antimigratory effects in cultured lung and prostate cancer cells.. J Med Chem, 51 (24): (8109-8114). [PMID:19053747] [10.1021/jm801077j] |
| 3. Rajput VK, MacKinnon A, Mandal S, Collins P, Blanchard H, Leffler H, Sethi T, Schambye H, Mukhopadhyay B, Nilsson UJ.. (2016) A Selective Galactose-Coumarin-Derived Galectin-3 Inhibitor Demonstrates Involvement of Galectin-3-glycan Interactions in a Pulmonary Fibrosis Model.. J Med Chem, 59 (17): (8141-8147). [PMID:27500311] [10.1021/acs.jmedchem.6b00957] |
| 4. Gabr M,Rehman AU,Chen HF. (2020) Quinoline-Pyrazole Scaffold as a Novel Ligand of Galectin-3 and Suppressor of TREM2 Signaling.. ACS Med Chem Lett, 11 (9): (1759-1765). [PMID:32944144] [10.1021/acsmedchemlett.0c00330] |
| 5. Raz, A A and 5 more authors.. (1991) Molecular cloning and chromosomal mapping of a human galactoside-binding protein.. Cancer research, (15): [PMID:2009535] |
| 6. Oda, Y Y, Leffler, H H, Sakakura, Y Y, Kasai, K K and Barondes, S H SH.. (1991) Human breast carcinoma cDNA encoding a galactoside-binding lectin homologous to mouse Mac-2 antigen.. Gene, (15): [PMID:2022338] |
| 7. Robertson, M W MW, Albrandt, K K, Keller, D D and Liu, F T FT.. (1990) Human IgE-binding protein: a soluble lectin exhibiting a highly conserved interspecies sequence and differential recognition of IgE glycoforms.. Biochemistry, (4): [PMID:2261464] |
| 8. Cherayil, B J BJ, Chaitovitz, S S, Wong, C C and Pillai, S S.. (1990) Molecular cloning of a human macrophage lectin specific for galactose.. Proceedings of the National Academy of Sciences of the United States of America, [PMID:2402511] |
| 9. Lotz, M M MM and 6 more authors.. (1993) Decreased expression of Mac-2 (carbohydrate binding protein 35) and loss of its nuclear localization are associated with the neoplastic progression of colon carcinoma.. Proceedings of the National Academy of Sciences of the United States of America, (15): [PMID:7682704] |
| 10. Huflejt, M E ME, Turck, C W CW, Lindstedt, R R, Barondes, S H SH and Leffler, H H.. (1993) L-29, a soluble lactose-binding lectin, is phosphorylated on serine 6 and serine 12 in vivo and by casein kinase I.. The Journal of biological chemistry, (15): [PMID:8253806] |
| 11. Kadrofske, M M MM, Openo, K P KP and Wang, J L JL.. (1998) The human LGALS3 (galectin-3) gene: determination of the gene structure and functional characterization of the promoter.. Archives of biochemistry and biophysics, (1): [PMID:9439577] |
| 12. Sasaki, T T, Brakebusch, C C, Engel, J J and Timpl, R R.. (1998) Mac-2 binding protein is a cell-adhesive protein of the extracellular matrix which self-assembles into ring-like structures and binds beta1 integrins, collagens and fibronectin.. The EMBO journal, (16): [PMID:9501082] |
| 13. Seetharaman, J J and 5 more authors.. (1998) X-ray crystal structure of the human galectin-3 carbohydrate recognition domain at 2.1-A resolution.. The Journal of biological chemistry, (22): [PMID:9582341] |
| 14. Heilig, Roland R and 98 more authors.. (2003) The DNA sequence and analysis of human chromosome 14.. Nature, (6): [PMID:12508121] |
| 15. Fukushi, Jun-ichi J, Makagiansar, Irwan T IT and Stallcup, William B WB.. (2004) NG2 proteoglycan promotes endothelial cell motility and angiogenesis via engagement of galectin-3 and alpha3beta1 integrin.. Molecular biology of the cell, [PMID:15181153] |
| 16. Seidel, Ronald D RD, Zhuang, Tiandi T and Prestegard, James H JH.. (2007) Bound-state residual dipolar couplings for rapidly exchanging ligands of His-tagged proteins.. Journal of the American Chemical Society, (18): [PMID:17385862] |
| 17. Than, Nandor Gabor NG and 24 more authors.. (2009) A primate subfamily of galectins expressed at the maternal-fetal interface that promote immune cell death.. Proceedings of the National Academy of Sciences of the United States of America, (16): [PMID:19497882] |
| 18. Haudek, Kevin C and 5 more authors.. (2010) Dynamics of galectin-3 in the nucleus and cytoplasm.. Biochimica et biophysica acta, [PMID:19616076] |
| 19. Zhou, Houjiang H and 6 more authors.. (2013) Toward a comprehensive characterization of a human cancer cell phosphoproteome.. Journal of proteome research, (4): [PMID:23186163] |
| 20. Escoda-Ferran, Cristina C and 8 more authors.. (2014) Modulation of CD6 function through interaction with Galectin-1 and -3.. FEBS letters, (25): [PMID:24945728] |
| 21. Chauhan, Santosh S and 11 more authors.. (2016) TRIMs and Galectins Globally Cooperate and TRIM16 and Galectin-3 Co-direct Autophagy in Endomembrane Damage Homeostasis.. Developmental cell, (10): [PMID:27693506] |
| 22. Thomas R Burkard,Melanie Planyavsky,Ines Kaupe,Florian P Breitwieser,Tilmann Bürckstümmer,Keiryn L Bennett,Giulio Superti-Furga,Jacques Colinge. (2011-01-29) Initial characterization of the human central proteome.. BMC systems biology, 5 (17-17). [PMID:21269460] |